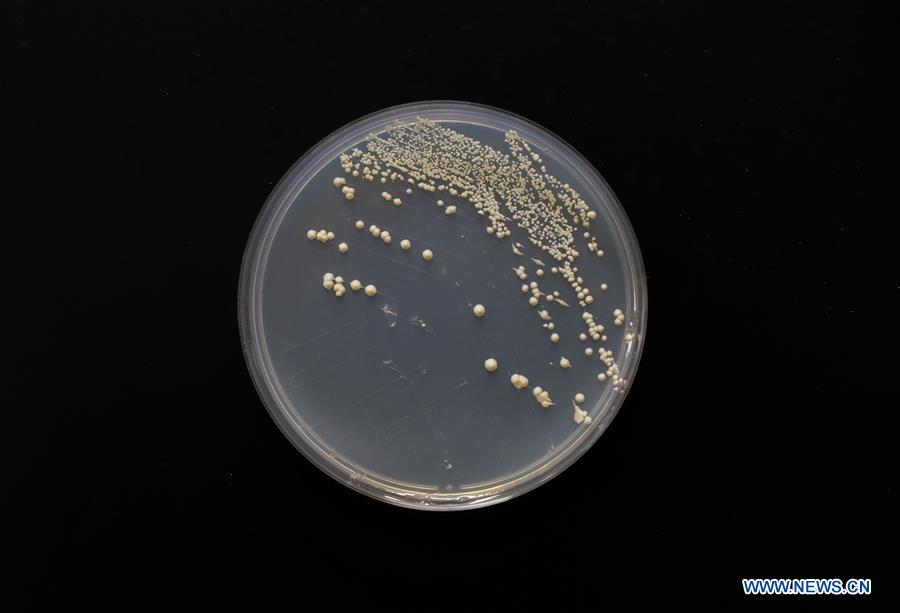
XINHUA PHOTO WEEKLY CHOICES

Photo taken on July 31, 2018 shows single chromosome yeast strain at the Center for Excellence in Molecular Plant Sciences of the Shanghai Institute of Plant Physiology and Ecology in Shanghai, east China. Chinese scientists have performed genetic surgery to create first single-chromosome yeast. (Xinhua/Ding Ting)?















